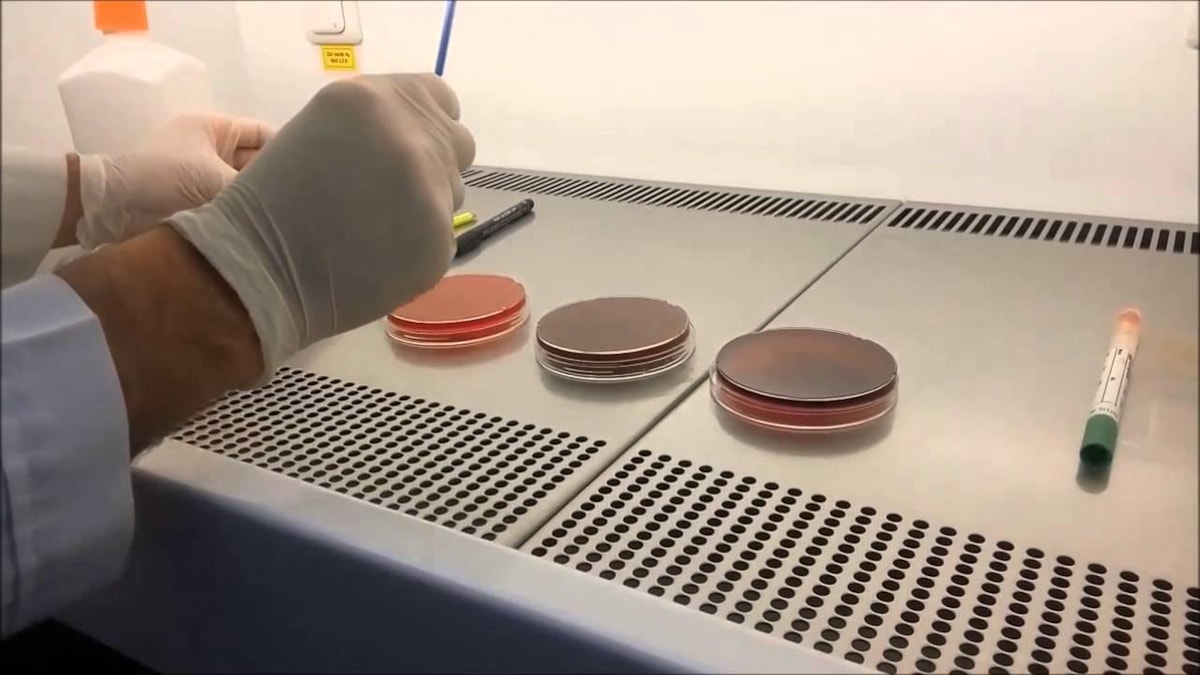

11 ili etkileyen depremler sonrasında bölgede salgın hastalık riski tartışılmaya başlanmıştı.
Sağlık Bakanlığı’na bağlı Halk Sağlığı ekipleri, salgın hastalık riskine karşı depremin vurduğu illerden biri olan Hatay’ın çeşitli bölgelerinde yaşayan vatandaşlardan gaita örneği alarak mobil laboratuvarda inceldiği bildirildi.
Gaita, aslında dışkıdır; Yediğimiz besinlerin bağırsak ve mide sisteminde sindirilmesi ve vücut için gerekli olan maddelerin emilmesinin ardından safra ve diğer vücut atıkları ile beraber vücuttan atılan bir kısımdır.
Hastalık olup olmadığının anlaşılmasını sağlayan Gaita testi merak konusu oldu. Gaita testi nedir nasıl yapılır soruları gündemde yer aldı.
Peki, Gaita nedir, Gaita testi nasıl yapılır? İşte hakkında bilgiler...
Tanı koymak için uygulanan bir tahlil yöntemi olan Gaita testi, dışkı örneği alınarak yapılır.
Gaita halk arasında "dışkı, büyük abdest, kaka" olarak bilinmektedir.
Gaita testinin amacı:
- Bağırsak enfeksiyonları
- Kolon kanserinin teşhisi
- Parazitin üreyip üremediği
- Sindirim sistemindeki sıkıntılar
- Dışkıda kan ve iltihap içeren hücrelerin olup olmadığının tespit edilmesi
- Kabızlık, ishal veya dışkıda tespit edilen bazı problemlerin ortaya çıkarılmasıdır.

Gaita testi nasıl yapılır
Gaita bir kutu içerisine alınarak laboratuvara teslim edilmektedir. Boşaltımda görev alan organların ve mekanizmaların düzgün işlediğini belirten gaita oluşumu, kişinin sağlığının göstergesidir.
Gaita testi sayesinde gaitanın kıvam, renk ve kokusu kadar, içerisinde mevcut gıda atıklarının özellikleri, mikroorganizmaların çeşitleri ve miktarları, safra içeriği gibi önemli parametreler incelenir.